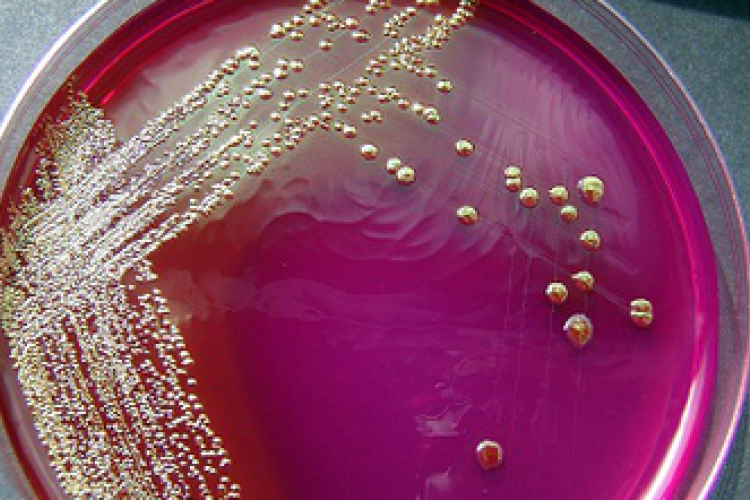
Az új kórokozók kihívást okoznak a szakembereknek

Hírek
2013. Május 16. 05:00, csütörtök |
Az új kórokozók kihívást okoznak a szakembereknek

2013. Május 16. 05:00, csütörtök |
A nők immunrendszere lassabban öregszik egy tanulmány szerint
A nők azért élnek hosszabb ideig, mint a férfiak, mert immunrendszerük lassabban öregszik - derítette ki egy japán tudósok által publikált tanulmány.

2013. Május 16. 05:00, csütörtök |
Összeomlott Som Lajos, mert elhagyta a felesége
Újra a pszichiátrián a Piramis egykori basszusgitárosa

2013. Május 15. 19:05, szerda |
Havazással kísért viharok Angliában
Havazással kísért szélviharok sújtják Anglia több térségét.

2013. Május 15. 19:01, szerda |
Eurovíziós Dalfesztivál - Bonnie Tyler és a Cascada az esélyekről

2013. Május 15. 18:58, szerda |
Kiraboltak egy pénzintézetet Debrecenben

2013. Május 15. 15:45, szerda |
Teke-vb - Tóth Katalin két aranyérmet szerzett

2013. Május 15. 15:43, szerda |
Kizárta magát a kapitány a pilótafülkéből

2013. Május 15. 15:12, szerda |
Angie leamputáltatta melleit
Angelina Jolie megrázó bejelentéséről és cikkéről szólt ma úgy a sajtó, mint minden női csevej. A sikeres anya, feleség, színésznő és filmrendező megvált melleitől. Mi képesek lennénk rá?

2013. Május 15. 13:40, szerda |
Gombahálózaton 'beszélgetnek' a növények
Földalatti gombahálózaton értekeznek egymással a növények: képesek figyelmeztető jeleket küldeni a többieknek a rájuk telepedő levéltetvekről - fedezték fel brit kutatók.

2013. Május 15. 12:51, szerda |
Pénzügyi okok miatt marad el A Tánc Fesztiválja Veszprémben
A pénzügyi okok miatt idén biztosan nem rendezik meg A Tánc Fesztiválját Veszprémben - tájékoztatták a szervezők az MTI-t kedden.

2013. Május 15. 12:49, szerda |
Jobbik: 'a Miniszterelnökség kisbuszaival hozzák-viszik Szijjártó Péter focicsapatát'


